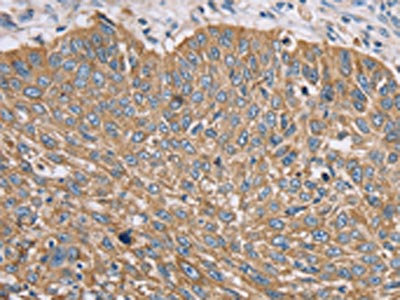

TFRC Antibody
-
中文名稱:TFRC兔多克隆抗體
-
貨號:CSB-PA104885
-
規格:¥1100
-
圖片:
-
The image on the left is immunohistochemistry of paraffin-embedded Human lung cancer tissue using CSB-PA104885(TFRC Antibody) at dilution 1/35, on the right is treated with synthetic peptide. (Original magnification: ×200)
-
The image on the left is immunohistochemistry of paraffin-embedded Human brain tissue using CSB-PA104885(TFRC Antibody) at dilution 1/35, on the right is treated with synthetic peptide. (Original magnification: ×200)
-
Gel: 6%SDS-PAGE, Lysate: 40 μg, Lane 1-2: 231 cells, Jurkat cells, Primary antibody: CSB-PA104885(TFRC Antibody) at dilution 1/200, Secondary antibody: Goat anti rabbit IgG at 1/8000 dilution, Exposure time: 20 seconds
-
-
其他:
產品詳情
-
Uniprot No.:
-
基因名:
-
別名:CD 71 antibody; CD71 antibody; CD71 antigen antibody; IMD46 antibody; OTTHUMP00000208523 antibody; OTTHUMP00000208524 antibody; OTTHUMP00000208525 antibody; p90 antibody; sTfR antibody; T9 antibody; TFR 1 antibody; TfR antibody; TfR1 antibody; TFR1_HUMAN antibody; TFRC antibody; TR antibody; Transferrin receptor (p90 CD71) antibody; Transferrin receptor protein 1; serum form antibody; Trfr antibody
-
宿主:Rabbit
-
反應種屬:Human,Mouse,Rat
-
免疫原:Synthetic peptide of Human TFRC
-
免疫原種屬:Homo sapiens (Human)
-
標記方式:Non-conjugated
-
抗體亞型:IgG
-
純化方式:Antigen affinity purification
-
濃度:It differs from different batches. Please contact us to confirm it.
-
保存緩沖液:-20°C, pH7.4 PBS, 0.05% NaN3, 40% Glycerol
-
產品提供形式:Liquid
-
應用范圍:ELISA,WB,IHC
-
推薦稀釋比:
Application Recommended Dilution ELISA 1:1000-1:2000 WB 1:200-1:1000 IHC 1:25-1:100 -
Protocols:
-
儲存條件:Upon receipt, store at -20°C or -80°C. Avoid repeated freeze.
-
貨期:Basically, we can dispatch the products out in 1-3 working days after receiving your orders. Delivery time maybe differs from different purchasing way or location, please kindly consult your local distributors for specific delivery time.
-
用途:For Research Use Only. Not for use in diagnostic or therapeutic procedures.
相關產品
靶點詳情
-
功能:Cellular uptake of iron occurs via receptor-mediated endocytosis of ligand-occupied transferrin receptor into specialized endosomes. Endosomal acidification leads to iron release. The apotransferrin-receptor complex is then recycled to the cell surface with a return to neutral pH and the concomitant loss of affinity of apotransferrin for its receptor. Transferrin receptor is necessary for development of erythrocytes and the nervous system. A second ligand, the heditary hemochromatosis protein HFE, competes for binding with transferrin for an overlapping C-terminal binding site. Positively regulates T and B cell proliferation through iron uptake. Acts as a lipid sensor that regulates mitochondrial fusion by regulating activation of the JNK pathway. When dietary levels of stearate (C18:0) are low, promotes activation of the JNK pathway, resulting in HUWE1-mediated ubiquitination and subsequent degradation of the mitofusin MFN2 and inhibition of mitochondrial fusion. When dietary levels of stearate (C18:0) are high, TFRC stearoylation inhibits activation of the JNK pathway and thus degradation of the mitofusin MFN2.; (Microbial infection) Acts as a receptor for new-world arenaviruses: Guanarito, Junin and Machupo virus.
-
基因功能參考文獻:
- TFR1 was increased in myelodysplastic syndrome patients and expression was upregulated in CD34+ cells from patients with refractory anaemia with ringed sideroblasts (RARS). PMID: 28714470
- palmitoylation is reported as a hitherto unreported level of post-translational TfR1 regulation. PMID: 29395073
- Our data provide evidence that blocking TfR could significantly inhibit lung adenocarcinoma (LAC) proliferation by targeting the oncogene KRAS; therefore, TfR may be a therapeutic target for LAC. In addition, our results suggest a new method for blocking the signal from the oncogene KRAS by targeting TfR in LAC. PMID: 29286585
- TfR could be used as a marker of erythropoiesis in high-flux hemodialysis patients PMID: 28446125
- The results suggest a role of microRNAs in the TfR1 regulation in the iron-regulatory protein-iron-responsive element system. PMID: 29295890
- Cell viability and surface expression of transferrin receptor (CD71) and glycophorin A (GPA) were analyzed before and after re-culture by flow cytometry. These studies show differential sensitivities of these surface proteins on K562 cells to proteases, and suggest molecular mechanisms of transmembrane protein transport and cycling. PMID: 28980921
- These data show that TfR1-PvRBP2b invasion pathway is critical for the recognition of reticulocytes during P. vivax invasion. PMID: 29302006
- combination of desferal with oxaliplatin can overcome cervical cancer oxaliplatin resistance through the regulation of hCtr1 and TfR1 PMID: 27384479
- Data suggest that hematologic parameters in children consuming lacto-ovo vegetarian diets are comparable with those of control children, but ferritin levels are lower; inclusion of novel serum biomarkers, soluble transferrin receptor and hepcidin, in nutritional assessment can better detect subclinical iron deficiency in children following vegetarian diet. This study was conducted in Poland with children ages 4.5-9 years. PMID: 28342014
- results suggest that lower Hepcidin-25, as well as higher sTfR and sTfR/Hepcidin-25 ratio were significant predictors of favorable hemoglobin response within a month after IV administration of ferric carboxymaltose in patients with CKD PMID: 27282576
- TfR1 was highly expressed in glioblastomas and associated with shorter survival in the whole cohort, but not in the individual malignancy grades PMID: 28837569
- Expression of Hepcidin and Ferroportin in the Placenta, and Ferritin and Transferrin Receptor 1 Levels in Maternal and Umbilical Cord Blood in Pregnant Women with and without Gestational Diabetes PMID: 27483296
- Human melanoma cells are able to up-regulate TFRC expression using hyaluronan/CD44 signaling. PMID: 28551638
- the group with homozygous or compound heterozygous state for beta-thalassemia had the highest sTfR1 levels and that the presence of increased sTfR1 levels (>5 times normal) was associated with a complex and severe history of disease requiring splenectomy, occasional red blood cells transfusions, and early start and continuous iron chelation therapy PMID: 28707012
- high expression of transferrin receptor-1 resulting in iron uptake contributes to increase in the labile iron pool which plays roles in cholangiocarcinoma progression with aggressive clinical outcomes. PMID: 28671021
- EGFR regulates iron homeostasis to promote non-small cell lung cancer growth through redistribution of transferrin receptor 1. PMID: 27523281
- TFR1 is overexpressed in adult T-cell leukemia/lymphoma caells . PMID: 28189691
- NSF deficiency in HeLa cells barely affected cell viability, anterograde trafficking of vesicular stomatitis virus glycoprotein G and transferrin endocytosis. PMID: 27995606
- inhibition of c-Abl minimizes receptor recycling pathways and results in chaperone-dependent trafficking of the TfR1 to the lysosome for degradation. PMID: 27226592
- alpha6(high)/CD71(low) cells give rise to a thicker pluristratified epithelium with lower seeding density and display a low Ki67 positive cells number, showing that they have reached the balance between proliferation and differentiation. PMID: 28134816
- Data show that the concentration of soluble transferrin receptor with high diagnostic value in the detection of iron deficiency-based anemia in patients undergoing dialysis for chronic renal failure at the end-stage. PMID: 27629729
- inverse correlation between the total percentage of CD71-positive NRBCs and gestational age suggests that this analysis may help in pregnancy dating PMID: 25906120
- Data indicate an over-expression of transferrin receptor 1 (TFRC) in hepatocellular carcinoma (HCC) and a markedly decreased level of microRNA-152 (miR-152) when compared to non-tumor liver tissue. PMID: 26657500
- Together, our findings reveal that TfR1 can contribute to the mitochondrial respiration and ROS production, which have essential roles in growth and survival of pancreatic cancer. PMID: 26869514
- siRNA targeted delivery using transferrin-coupled lipoplexes specifically sensitizes CD71 high expressing malignant cells to antibody-mediated complement attack PMID: 25395366
- Case Report: cellular iron deficit due to the low level of transferrin receptor, particularly in erythroid tissue. PMID: 26339443
- The requirement for a threshold level of TFR1 expression can explain why among primary human hematopoietic cells, only erythroblasts efficiently take up H-ferritin. PMID: 26441243
- Data indicate only the glycoproteins CD34+/CD71low population showed statistically significant differences between Diamond-Blackfan Anaemia (DBA) patients and controls. PMID: 26394034
- These results demonstrate that in cells expressing the hTfR, Tacaribe virus internalization depends on the presence of cholesterol, dynamin and acidic intracellular vesicles. PMID: 26559962
- The importance of TfR1 in adaptive immunity.A missense mutation in TFRC, encoding transferrin receptor 1, causes combined immunodeficiency. PMID: 26642240
- The blood levels of TfRC was higher in age-related macular degeneration patients than controls.No association was found between age-related macular degeneration occurrence and the p.Gly142Ser polymorphism of the TRFC gene. PMID: 25915522
- Data show that interleukin 6 (IL-6) secretion and the percentage of CD71 antigen-positive T lymphocytes both uniquely predicted survival independent of papillomavirus infection status. PMID: 26079381
- This study provides insights into the effector functions of human IgG3 in the context of an antibody targeting TfR1. PMID: 26232328
- this report provided a convenient protocol that could be fulfilled in order to prepare hTfR1 inclusion body, which failed to be purified by an Ni(2+) affinity column. PMID: 25207990
- elucidation of a signalling pathway whereby C18:0 stearoylates TFR1, thereby inhibiting its activation of JNK signaling; this leads to reduced ubiquitination of mitofusin via HUWE1, thereby promoting mitochondrial fusion and function PMID: 26214738
- The surface levels of three receptors [TfR, epidermal growth factor receptor (EGFR) and beta1 integrin] were tested and found to be reduced dependent on Escherichia coli EspG translocation. PMID: 24898821
- High TFRC expression is associated with response to low intravenous immunoglobulin therapy in patients with Kawasaki disease. PMID: 25449331
- The rate of TFRC expression in oral sqamous cell neoplasms was significantly higher than that in dysplasia, suggesting that it may be involved in disease progression. PMID: 24890018
- CD71 is useful for the evaluation of differentiation stage for AML cells. PMID: 23962073
- these findings suggest that TFR1 has an important role in sphingosine kinase 1-mediated oncogenesis. PMID: 24276247
- a critical review the available literature to assess the diagnostic efficacy of sTfR in complicated anemia--{REVIEW} PMID: 24525213
- Expression of the transferrin receptor CD71 is associated with clinical features of esophageal squamous cell carcinoma. PMID: 24435655
- results suggest that Transferrin or a TF-TFR2 complex may have a role in the etiology of PD, possibly through iron misregulation or mitochondrial dysfunction within dopaminergic neurons. PMID: 24121126
- high levels of TfRs such as those found on activated lymphocytes were found to be associated with decreased KLRG1 inhibitory function, indicating that TfRs may sequester KLRG1 from interacting with cadherins. PMID: 24752778
- MARCH 8 mediates the ubiquitination and lysosomal degradation of the transferrin receptor. PMID: 23606747
- A statistically significant difference in urinary sTfR concentration was observed between patients with active IgA nephropathy or Henoch-Schonlein purpura nephritia and patients who had achieved partial or complete remission PMID: 23384534
- The kinesin KIF16B mediates apical transcytosis of transferrin receptor in AP-1B-deficient epithelia. PMID: 23749212
- Knockdown of Rab12 increased transferrin receptor level and reduced M98K-induced cell death. PMID: 23357852
- TfR1 plays a role in hepatitis C virus (HCV) infection at the level of glycoprotein-mediated entry, acts after CD81, and possibly is involved in HCV particle internalization. PMID: 23754414
- Among the PC family members, only furin activates hepcidin in hepatocytes, and uniquely the full-length membrane-bound PC7 can directly shed hTfR1 by cleavage at Arg100 PMID: 23390091
顯示更多
收起更多
-
相關疾病:Immunodeficiency 46 (IMD46)
-
亞細胞定位:Cell membrane; Single-pass type II membrane protein. Melanosome.; [Transferrin receptor protein 1, serum form]: Secreted.
-
蛋白家族:Peptidase M28 family, M28B subfamily
-
數據庫鏈接:
Most popular with customers
-
-
YWHAB Recombinant Monoclonal Antibody
Applications: ELISA, WB, IHC, IF, FC
Species Reactivity: Human, Mouse, Rat
-
Phospho-YAP1 (S127) Recombinant Monoclonal Antibody
Applications: ELISA, WB, IHC
Species Reactivity: Human
-
-
-
-
-